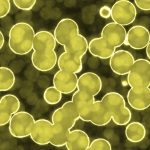

ATENȚIE, PĂRINȚI! E-țigaretele devin o capcană mortală pentru copii!
Un nou fenomen îngrijorător își face simțită prezența la nivel global: dependența de e-țigarete, care afectează milioane de tineri! Organizația Mondială a Sănătății (OMS) trage un semnal de alarmă, avertizând asupra impactului devastator al acestor produse asupra sănătății copiilor.
Un val de dependență în creștere
În timp ce numărul adulților fumători scade, tinerii devin din ce în ce mai atrași de țigaretele electronice. Statistici îngrijorătoare arată că adolescenții cu vârste între 13 și 15 ani sunt de nouă ori mai predispuși să folosească e-țigarete decât adulții! Peste 100 de milioane de persoane din întreaga lume sunt utilizatori, iar aproximativ 15 milioane dintre aceștia sunt copii!
Industria tutunului țintește tinerii
Experții subliniază că industria tutunului promovează e-țigaretele ca fiind o alternativă „mai sigură”, dar adevărul este cu totul diferit. Aceste companii vizează tinerii, având ca rezultat creșterea dependenței și compromiterea progreselor în combaterea fumatului. Marketingul agresiv al industriei își propune să atragă noi generații de consumatori, iar cifrele vorbesc de la sine.
Scăderea fumătorilor adulți, dar nu și a dependenței
De la începutul anilor 2000, numărul fumătorilor a scăzut de la 1,38 miliarde la 1,2 miliarde, însă un adult din cinci rămâne dependent de tutun. Industria continuă să dezvolte produse pe bază de nicotină pentru a menține aceste cifre alarmante, în ciuda eforturilor globale de reducere a consumului de tutun.
O amenințare majoră pentru sănătate
Tabagismul reprezintă o amenințare gravă pentru sănătate, ucigând anual peste șapte milioane de oameni. Expunerea la fumul pasiv cauzează și ea un milion de decese suplimentare. În 12 țări, prevalența fumatului este în creștere, expunând milioane de oameni la riscuri serioase.
Apel la acțiune! Guvernele trebuie să acționeze rapid și ferm, aplicând politici anti-tutun eficiente pentru a proteja sănătatea copiilor și a populației în ansamblu! Este timpul să ne unim forțele și să luptăm împotriva acestei capcane mortale!
Etichete: apel acțiune dependență e-țigarete industrie tutun sănătate copii